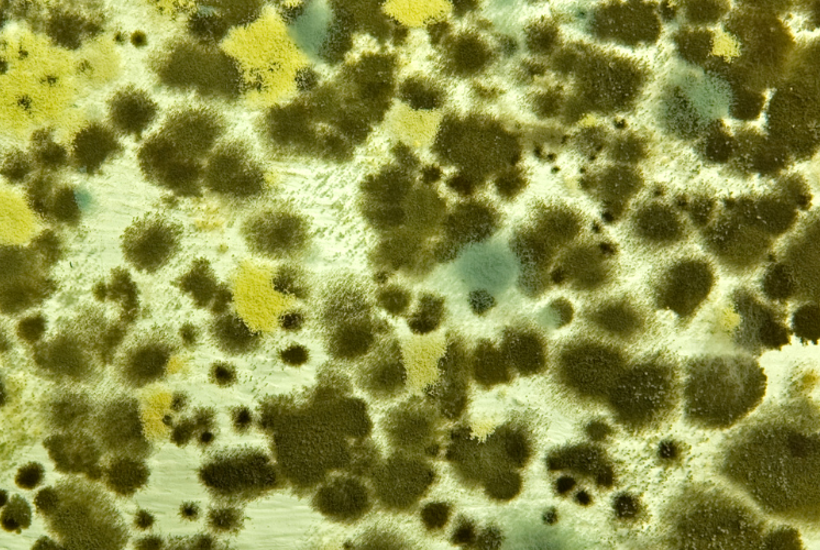
Skimmelsvamp er blevet resistent over for medicin pga. sprøjtemidler

Skimmelsvamp er blevet resistent over for medicin pga. sprøjtemidler

- Drikkevand
- Landbrug
- 11. marts 2025
Danmarks Naturfredningsforening har i mange år kæmpet for et forbud mod de såkaldte azol-midler, som bruges til svampebekæmpelse i korn og andre afgrøder som kartofler.
Stofferne er mistænkt for at have hormonforstyrende effekter og nedbrydningsproduktet 1,2,4-triazol findes i stort omfang i det øvre grundvand, som i dag forsyner 400.000 danskere med drikkevand.
Derudover er azolmidlerne, når de spredes i miljøet, med til at skabe resistente bakterier, som ikke kan behandles med medicin. Statens Serum Institut har tidligere påvist, at langt størstedelen af de resistente svampeinfektioner hos undersøgte patienter, havde en miljøresistens variation af svampen. Det betyder, at svampen har udviklet resistens som forsvar mod menneskets brug af svampegift i fx landbruget.
Nu dokumenterer en ny rapport fra Miljøstyrelsen, at de resistente bakterier findes næsten overalt i Danmark. Forskerne finder den resistente Aspergillus fumigatus-svamp overalt, hvor de leder: korn- og kartoffelmarker, potteplanter, jord på kartofler, kompostbunker, møddinger med hestemøg, parker, kolonihaver og sågar en have tilhørende Statens Serum Institut. Der skriver Politiken.
366 prøver indgår i undersøgelsen, og kun 3 prøvetyper frikendes: jorden i en potteplante med kaktus, de renvaskede kartofler i supermarkedsposer og frisk staldstrøelse af halm og tørv. Alle andre steder dokumenterede forskerne den resistente skimmelsvamp.
- Vi var alle sammen lidt overraskede over, at vi fandt dem så universelt, også på steder, hvor vi er stensikre på, at der ikke er sprøjtet med noget som helst. Det siger professor Maiken Cavling Arendrup fra Statens Serum Institut, forfatter af rapporten fra Miljøstyrelsen, til Politiken.
Landbruget benytter i stor stil en række sprøjtemidler baseret på stofgruppen azoler til at bekæmpe svampeangreb. De største mængder går til kornmarker, som dækker det største areal, men kartofler er den mest intensivt sprøjtede afgrøde.
Azoler er samtidig det aktive stof i lægemidler mod infektion med Aspergillus fumigatus. Der findes, understreger Maiken Cavling Arendrup overfor Politiken, kun få lægemidler, og azoler er de mest effektive og de eneste, der fås som tabletter.
Kun stærkt svækkede patienter bliver ramt af infektion med Aspergillus fumigatus. Det gælder blandt andet kronisk syge og patienter i behandling for knoglemarvskræft, som er på immundæmpende medicin.
Mennesker indånder hver dag et sted mellem 10 og 100 sporer fra skimmelsvampen. I gennemsnit er godt 4 procent af svampene resistente.
Der findes ingen nøjagtig opgørelse over antallet af patienter med infektion med skimmelsvamp, som landbrugets sprøjtemidler har gjort resistent over for medicinen. Men da cirka 500 årligt rammes af en infektion med Aspergillus fumigatus, og da godt 3 procent af analyserne fra patienter viser resistens, estimerer Maiken Cavling Arendrup, at det drejer sig om mellem 15 og 20 personer.
-Det er ikke noget tårnhøjt tal, men de er i høj risiko for at dø, siger hun til Politiken.
Præsident i Danmarks Naturfredningsforening Maria Reumert Gjerding ønsker et forbud mod azol-midler ud fra et forsigtighedsprincip.
-Vi har i mange år advaret mod den stigende brug og anbefalet et forbud mod de her midler. Det går ikke, at der er i Folketinget og regeringen er så stor en berøringsangst for at gribe ind overfor landbrugets brug af sprøjtemidler, siger hun.
Miljøstyrelsen indførte i 2014 begrænsninger for den samlede mængde svampemidler, men det har ikke begrænset brugen af azolholdige pesticider.
- Man har ikke kunne nedbringe salget af azolmidler, der ifølge rapporten har ligget omkring 200 tons årligt. Så den nye rapport er et vink med en vognstang - politikerne bliver altså nødt til at gribe ind nu, siger Maria Reumert Gjerding.